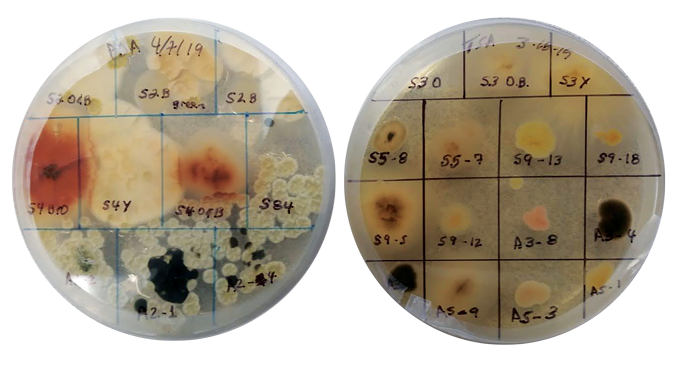
two petri dishes with smoke microbe samples

Wildfire smoke seeds the air with potentially dangerous microbes
Researchers now worry about what health risks these living microbes pose

Smoke billows from the Apple Fire in Cherry Valley, Calif., on August 1, 2020. Such wildfires can shoot flames, smoke — and microbes — high into the air. Scientists are now trying to measure how much such fires contribute to the spreading of infectious disease.
David McNew/Getty Images
Share this:
- Share via email (Opens in new window) Email
- Share on Facebook (Opens in new window) Facebook
- Share on X (Opens in new window) X
- Share on Pinterest (Opens in new window) Pinterest
- Share on Reddit (Opens in new window) Reddit
- Share to Google Classroom (Opens in new window) Google Classroom
- Print (Opens in new window) Print
By Megan Sever
A rare fungal infection has been spreading throughout the western United States. In a little more than two decades, cases in Arizona and California have climbed more than sixfold. Called Valley fever, the disease can cause coughing, fever, chest pain — even death.
The fungi responsible can be found throughout California and the desert Southwest. Firefighters are especially vulnerable. In fact, wildfires appear to stir up the soil-loving fungi, flinging them into the air. From there they can be inhaled deeply into our lungs.
Rising temperatures and worsening droughts have led to longer and more intense wildfire seasons across the American West. On its own, wildfire smoke can make people sick. It’s been linked to causing everything from heart disease and lung illnesses to eczema. One 2018 study found that in the United States alone, wildfire smoke causes some 17,000 premature deaths each year — a number that could double by 2100.
The most intense fires can create their own weather. A few have spawned firenadoes. Such hot and energetic storms can send smoke all the way into the stratosphere. That’s 14 to 64 kilometers (9 to about 31 miles) above Earth’s surface. From there, smoke can travel around the world, just as volcanic ash can.
If fires can loft Valley fever fungi, could they do the same for other microbes? A few years ago, Leda Kobziar decided to find out.
As a fire ecologist at the University of Idaho in Moscow, she began sampling for microbes in wildfire smoke. By 2018, she had launched a new research field. She calls it pyroaerobiology (PY-roh-air-oh-by-OL-oh-gee). It’s a long name for the idea that fires can move living things through the air.
Her work has come to show that many microbes can survive a fire’s searing heat.
But how far wildfire smoke can ferry bacteria and fungi is still a big unknown. Kobziar is now working with other scientists to answer that. Their goal: to learn how important smoke is to the widespread dispersal of disease-causing microbes.


Invisible but pervasive
Air may look clear, but “hundreds of different bacteria and fungi are blowing around” even the cleanest air, says Noah Fierer. He’s a microbiologist at the University of Colorado Boulder.
Winds whisk bacteria and fungi off farm fields, deserts, lakes and oceans. Once aloft, these microbes can travel the world. Indeed, billions of tons of dust blow off of deserts and farm fields each year. Winds act as a conveyor belt for microbes. Scientists have found microbes that started in the Sahara, for example, landing in the Caribbean.
Few airborne microbes are likely to cause disease, Fierer notes. But several can make people sick or trigger allergic reactions. Other smoke-hitchhiking microbes can cause disease in plants.
If dust can move living microbes around the globe, Kobziar thought, it made sense that tiny smoke aerosols could, too. Research by her team and others is now offering compelling evidence that smoke indeed ferries live microbes.
Microbes by the dishful
Kobziar and her students at the University of Florida in Gainesville collected the first air samples for this line of research in 2015. The samples came from planned burns in the school’s experimental forest. These fires had been set on purpose as part of a research project.
The group topped 3-meter-long (about 1-yard-long) poles with petri dishes. If microbes landed in the dishes, colonies of the microbes should grow. And that could make them easy to see and identify.
The team held the petri dishes in the air for three minutes before the fires. This collected normal levels of air microbes. Then Kobziar lit the fires. Flames quickly spread at a steady rate. As smoke began billowing, students hoisted new petri dishes into it, almost as if aiming a marshmallow on a stick at a campfire. This collected smoky air samples.
After Kobziar and her students covered and sealed the dishes, her team took the samples back to the lab and waited three days as the microbes began to grow. Far more bacterial and fungal species populated the smoky petri dishes than those that had been exposed to “clean” air. This showed that the fire aerosols had added some microbial species to those that had been in the air before the fire.
“We were stunned at how many different microbial colonies survived the combustion environment and grew,” Kobziar says. By comparison, there were “very few in the ambient air.” DNA tests identified 10 types of bacteria and fungi. Some can sicken plants. One is an ant parasite. Another one helps plants absorb nutrients.
From this moment on, Kobziar says, “the way we thought about smoke was completely transformed.”
Her team reported its findings in Ecosphere in 2018.
By 2017, Kobziar had moved to Idaho. Her team collected soil samples from a University of Idaho forest and burned them — this time, in the lab. Once more, they found smoke had hosted lots of surviving microbes — including fungi — which soon multiplied into big colonies.

Since then, Kobziar’s team has been collecting more air samples during intentional research burns in other states. Her team works with the U.S. Forest Service as part of its Fire and Smoke Model Evaluation Experiment, or FASMEE. For her students’ safety, Kobziar has replaced the poles and petri dishes with drones. As those robotic planes fly through smoke plumes, they sample the air.
And they have been turned up living bacteria and fungi in every parcel of smoke the drones have sampled.
In Utah, Kobziar says, the FASMEE team found more than 100 different fungi that were not in the air before the fire. This included species of Aspergillus, which can cause fevers, coughs and chest pain. They also turned up molds that can cause allergies and asthma.
Her team has not tested whether the species that survived the heat can cause disease, but it plans to test this.
Robust microbes
The Utah research also revealed these microbes are tough.
About six in every 10 bacterial and fungal cells in smoke were alive, Kobziar says — even in smoke from high-temperature fires. Even more, roughly eight in every 10 cells, seem to survive lower-intensity fires. Kobziar points out that’s “about the same percentage of cells we’d expect to see alive in [non-smoky] air.”
Her team’s studies are the first to show that fires are lofting live bacteria and fungi at least 120 meters (393 feet) above the ground — and close to a kilometer (0.6 mile) from the frontlines of a fire.
Still, many basic questions remain. How does the mix of microbes change — in quantity, type or viability — the farther you get from a fire? How high can they rise and how far can they travel? How do different types of fuel — pine trees, grasslands, deciduous trees or crops, for example — affect which microbes get into a fire’s smoke? Does the type of burning — such as a smolder (like a wet log on a campfire) versus a high-intensity flame — change what microbes are released? And how does fire temperature or weather (such as humidity) affect the microbes’ survival rates?
Answers could emerge if one of Kobziar’s dreams comes true. She longs to work with researchers on NASA’s DC-8 “flying laboratory.” It explores Earth’s surface and atmosphere for studies ranging from archaeology to volcanology.
Different chemicals released by fires have been tracked in the stratosphere from the Arctic to the South Pacific and everywhere in between, notes Christine Wiedinmyer. She works at the Cooperative Institute for Research in Environmental Sciences. It’s in Boulder, Colo. Researchers using the DC-8 sampled masses of high-altitude air looking for pollutants and how they react with other molecules in the air.

They’re finding traceable signatures of fires everywhere in the atmosphere. This suggests that fires could also be sending bacteria and fungi around the world, Wiedinmyer says. And this interests her. She has been tracking and using a computer to model the movement of chemicals in wildfire smoke around the world.
She sees no reason why such computer models couldn’t also be used to track and forecast the movement of microbes in smoke — once researchers collect enough data. That’s why “pyroaerobiology is so cool,” she says. These data might answer basic questions about the health hazards of smoke-carried microbes.
A U.S. map
Fierer’s team in Colorado is working to get a baseline of what microbes are in the air at different locations during normal times. Later, they’ll compare those to what they find in smoke. The group has been sampling indoor and outdoor air at hundreds of U.S. homes to “map out what microbes we’re breathing in as we’re walking around doing our daily business,” Fierer says. They also are sampling air across Colorado, which experienced record-breaking fires in 2020.

Microbes in the air can vary a lot. Near a Midwestern city in winter, for example, they might include ones associated with local trees or, strangely, dog feces. Near a Colorado feedlot in summer, microbes might include those associated with cattle feces.
Once scientists get the measurements of how many microbes can be carried in smoke, and to what altitudes, Fierer’s group can combine those data with global smoke-production numbers. Then they can compute “some back-of-the-envelope calculations” of the likely quantity of microbes traveling in smoke. Eventually, he says, scientists could figure out how many are alive, and whether that even matters for human health.
Big leaps forward could be made if more scientists get involved in such studies, Fierer and Kobziar say. Fortunately, researchers from different fields have shown interest in doing so. This was after a paper in Science, last December, summed up the state of pyroaerobiology and described questions that still need answers. Kobziar authored it along with infectious-disease physician George Thompson of the University of California, Davis.
Is there danger?
In recent years, Thompson has seen a big increase in patients getting fungal infections, such as Valley fever, after nearby wildfires. He was well aware that when smoke aerosols get into the lungs, they can make it hard to breathe. They can even trigger heart attacks. In fact, heavy smoke during California’s 2015 to 2017 wildfires raised the risk of heart attacks there by up to 70 percent. That’s according to an April 21, 2020 report in the Journal of the American Heart Association.
Thompson began to wonder if California’s record-breaking infernos were stirring up more microbes than the Valley fever fungus. So he’s now joined forces with Kobziar.
The Valley fever link appears real. For example, after the 2003 Simi Fire burned through Ventura County, more than 70 people came down with Valley fever. So far, no one knows how far the fungi that cause it can travel and sicken people.
There are, however, ways to find out. One way, Thompson says, is to compare a town’s antibiotic prescriptions and hospital visits in the months before and after a fire.
But until we know more about what microbes fires release and where they go, we won’t know how important such a link is for human health, Fierer says. There’s so much we don’t know yet, Thompson agrees. “We still have a lot of work to do. This is sort of the beginning of the beginning of the story.”
High-flying dust
In August 1965, scientists from England traveled to the Caribbean island of Barbados. There, they watched a mass of air blow in from 4,500 kilometers (2,800 miles) to the east. Within hours, air moving through their nets turned brick red with dust, recalls Joseph Prospero. He was a young scientist in Florida back then.
To find its source, Prospero sampled the air a year later from a plane high above the Atlantic Ocean. Winds 1 to 3 kilometers (0.6 to 1.9 miles) up were ferrying red dust from Africa to the Caribbean, he found. Other studies would show high-altitude winds elsewhere regularly move dust half-way round the world or more.
Such winds carry 3 billion to 4 billion tons of dust each year — enough to cover the city of Chicago, Ill., to a depth of 5 meters (16 feet). Some of the dust nourishes lush forests — allowing them to grow where otherwise they could not. Airborne dust also triggers rain and snowfall. It can even move microbes across oceans.
— Douglas Fox






